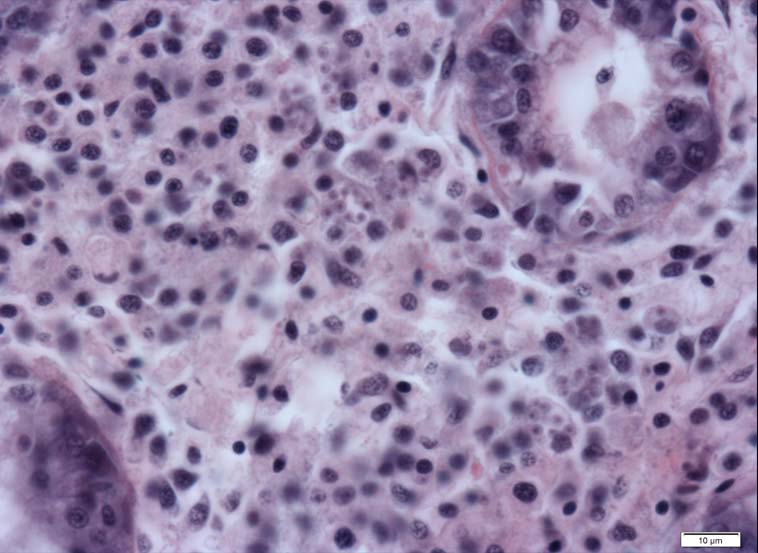
patogeno_ostra

Nuestro reto es alcanzar un desarrollo sostenible de nuestro entorno, para lo que estudiamos y aportamos el conocimiento de las costas y el medio marino desde una perspectiva integrada (características físicas, ecológicas y socioeconómicas del medio marino y sus interacciones) que ayude a la toma de decisiones por parte de las personas gestoras y usuarias del litoral.

Trabajamos en cinco ámbitos de aplicación:
Índice de contenidos
Impacto y vigilancia ambiental
Investigamos la evolución de la calidad ambiental en la zona litoral y desarrollamos nuevos indicadores ambientales
Llevamos a cabo, en el contexto del procedimiento de Evaluación de Impacto Ambiental (EIA), los Estudios de Impacto Ambiental (EsIA) y Planes de Vigilancia Ambiental (PVA), tanto de Planes y Programas (Evaluación Estratégica Ambiental, EEA), como de proyectos en el medio marino.
Evaluación del estado de salud del medio marino
Nuestra labor se dirige a determinar el estado ecológico y ambiental de las zonas estuáricas y costeras
Tales evaluaciones constituyen requerimientos de las principales directivas europeas en materia de protección y gestión del medio marino, como la Directiva Marco del Agua (DMA) y la Directiva de la Estrategia Marina Europea (DEME).
Investigamos la evolución de la calidad ambiental de los estuarios, zonas costeras y mar abierto y aplicamos y desarrollamos indicadores que den respuesta a la DMA, la DEME, los convenios internacionales (ej. OSPAR), y otras directivas (ej. Hábitats, Aguas de Baño, Zonas de Cultivo y Marisqueo, etc).
Conservación de los ecosistemas marinos
Trabajamos para conservar la biodiversidad marina (especies, hábitats, espacios, procesos) con el fin de conseguir una gestión sostenible de los recursos naturales
Realizamos estudios para la protección de las especies marinas amenazadas, para la declaración de reservas marinas y planteamos estrategias de recuperación de lugares sometidos a presiones humanas mediante la aplicación de medidas de gestión y restauración.
Bienes y servicios y planificación espacial marina
Evaluamos los servicios del ecosistema y los beneficios para la sociedad en términos de aprovisionamiento (alimento, materias primas), regulación (cambio climático, nutrientes) y culturales.
Se estudian las funciones del ecosistema que contribuyen a dichos servicios y las presiones e impactos antropogénicos sobre el medio natural, que afecten a dichas funciones.
Identificamos también las zonas para el desarrollo de nuevas actividades tales como la producción de energía renovable, acuicultura, y se analizan los posibles conflictos entre los nuevos usos y los tradicionales, con el objetivo de optimizar la explotación de los recursos naturales.
Asesoramos a las administraciones públicas en el establecimiento de planes integrales de gestión de la actividad costera (como planes de dragados y de la ordenación de la actividad acuícola, o control de vertidos al mar).
Ciencia y Sociedad
Tratamos de acercar las investigaciones que realizamos a la sociedad a través de la alfabetización marina
Trabajamos para intentar que la sociedad conozca los principales aspectos del funcionamiento de los ecosistemas marinos, las presiones a las que le sometemos a través de nuestras actividades y los beneficios que nos reporta el medio marino, de forma que se genere conciencia sobre su conservación y se promuevan cambios de comportamientos orientados hacia el respeto y el uso sostenible y responsable.